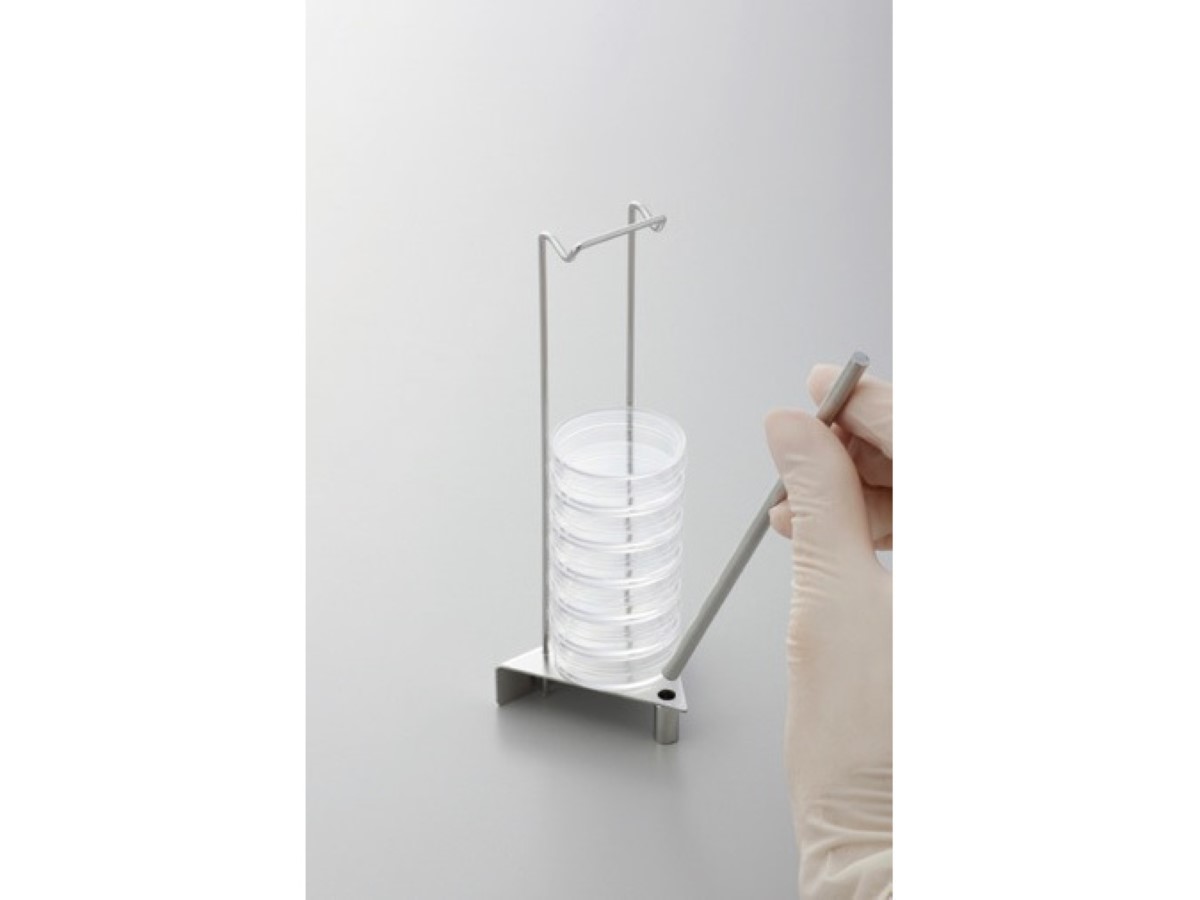

Dish Holder for φ35 mm (OKAMOCHI Series)
Description
●It is convenient for stacking and storing 35φ dishes and moving multiple dishes.
●Space-saving design that does not take up much space in the incubator.
●The main body is made of stainless steel.
●The main body is made of stainless steel and can be autoclaved.
● Maximum number of stacks: 9, recommended 4-5.
●The higher the stacks, the less effective the upper dish is in preventing the liquid level from shaking.
●Suitable dish diameter (outer diameter of the lid): 39-40mm
Caution
Specifications
Catalog No.
27300
Model
35-DH
Main body O.D(mm)
W60×D51×H152
Internal dimension (mm)
Bore(mm)
Body diameter×height(mm)
Spec 1
Spec 2
Spec 3
Spec 4
Shelf(pc)
Scale(mL)
Material
SUS
Weight(Kg)
Inquire about this product

One or more field is invalid!
Please check and try again.

Inquiry sent!
We’ll get back to you as soon as possible.